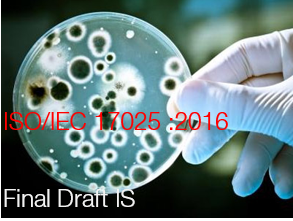

ISO/IEC FDIS 17025:2016
| ID 4580 | | Visite: 7365 | News generali | Permalink: https://www.certifico.com/id/4580 |
ISO/IEC Final Draft International Standard 17025:2016
General requirements for the competence of testing and calibration laboratories
Ultima fase prima della pubblicazione (Dicembre 2017)
Nel corso degli anni, ISO/IEC 17025, requisiti generali per la competenza dei laboratori di collaudo e di calibrazione , è diventato il riferimento internazionale per i laboratori di collaudo e calibrazione che vogliono dimostrare la loro capacità di fornire risultati attendibili.
Lo Standard Internazionale, pubblicato congiuntamente da ISO e IEC (International Electrotechnical Commission), contiene una serie di requisiti che permettono ai laboratori di migliorare la loro capacità di produrre risultati costantemente validi.
Questo standard è di grande importanza per la IEC Conformity Assessment Community in quanto definisce i requisiti fondamentali per i test in tutti gli schemi e programmi di valutazione della conformità che operano nei sistemi di valutazione della conformità IECEE, IECEx, IECQ e IECRE.
La revisione è stata avviata nel febbraio 2015 a seguito di una proposta congiunta della Cooperazione Internazionale per l'Accreditamento del Laboratorio (ILAC) e dell'Ufficio di Presidenza sudafricano (SABS), membro della ISO e ospita il Comitato Nazionale IEC. Il processo di revisione standard ha ora raggiunto la fase finale dello Standard Internazionale (FDIS), l'ultima tappa dello sviluppo prima della pubblicazione.
Le principali modifiche
La revisione di ISO/IEC 17025 tiene conto delle attività ed i nuovi modi di funzionamento dei laboratori di oggi.
Le principali modifiche sono le seguenti:
- L'approccio di processo si adatta ora a quelli più recenti come ISO 9001 (gestione della qualità), ISO 15189 (qualità dei laboratori medici) e ISO/IEC 17021-1 (requisiti per gli organismi di audit e certificazione). Lo standard rivisto pone l'accento sui risultati di un processo anziché sulla descrizione dettagliata dei suoi compiti e passaggi.
- Con una maggiore attenzione alle tecnologie dell'informazione, lo standard riconosce e incorpora l'utilizzo di sistemi informatici, registrazioni elettroniche e la produzione di risultati elettronici e report. I laboratori moderni lavorano sempre più con le tecnologie dell'informazione e della comunicazione e il gruppo di lavoro ha ritenuto necessario sviluppare un capitolo su questo argomento. La nuova versione dello standard include un capitolo sul pensiero basato sui rischi e descrive le comuni con la nuova versione di ISO 9001: 2015, Sistemi di gestione della qualità - requisiti.
- La terminologia è stata aggiornata per essere più in linea con il mondo odierno e il fatto che i manuali, i record e le segnalazioni di copie sono state gradualmente eliminate a favore delle versioni elettroniche. Esempi includono le modifiche al Vocabolario Internazionale di Metrologia (VIM) e l'allineamento con la terminologia ISO/IEC, che ha un insieme di termini e definizioni comuni per tutti gli standard dedicati alla valutazione della conformità.
È stata adottata una nuova struttura per allineare lo standard alle altre norme ISO/IEC esistenti per la valutazione della conformità come la serie ISO/IEC 17000 sulla valutazione della conformità.
Il campo di applicazione è stato rivisto per coprire tutte le attività di laboratorio, tra cui test, calibrazione e campionamento associati a successive calibrazioni e prove.
L'utilizzo di ISO/IEC 17025 facilita la cooperazione tra laboratori e altri organismi. Contribuisce allo scambio di informazioni e esperienze e aiuta ad armonizzare le norme e le procedure. Lo standard richiede loro di soddisfare i criteri per la competenza del proprio personale, la calibrazione e la manutenzione delle loro apparecchiature e i processi complessivi che utilizzano per generare i dati. Ciò richiede che i laboratori pensino e operino in modo da garantire che i loro processi siano sotto controllo e che i loro dati siano affidabili.
Lo scorso luglio a Ginevra si è svolta l’ultima riunione del Gruppo ISO CASCO WG 44, impegnato ormai da due anni nel processo di revisione della norma per l’accreditamento dei laboratori di prova e di taratura ISO/IEC 17025 “General requirements for the competence of testing and calibration laboratories”.
In questa occasione il WG 44 ha emesso il documento FDIS (Final Draft International Standard) della norma. L’emissione della nuova norma ISO/IEC 17025 è attesa entro Dicembre 2017.
La struttura della nuova norma appare sostanzialmente diversa dalla norma attuale edizione 2005, distribuendo i requisiti in 4 capitoli:
- Structural requirements,
- Resource requirements,
- Process requirements,
- Management requirements.
Fonte: ISO
https://www.iso.org/standard/66912.html
| Descrizione | Livello | Dimensione | Downloads | |
|---|---|---|---|---|
| ISO-CASCO-WG44_N0112_FDIS_ISOIEC_17025.pdf General requirements for the competence of testing and calibration laboratories |
715 kB | 14 |
Tags: Normazione Norme ISO